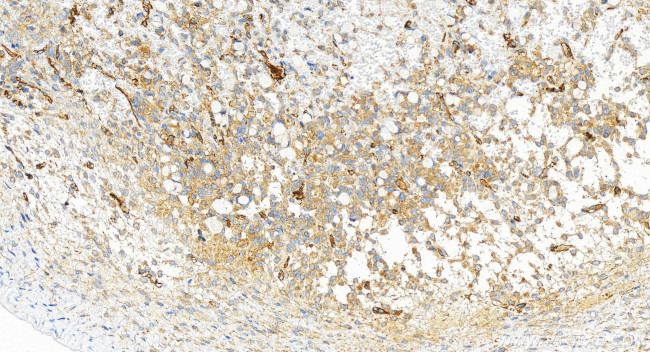
PTPN12 Antibody in Immunohistochemistry (Paraffin) (IHC (P))

Search
Proteintech
PTPN12 Recombinant Rabbit Monoclonal Antibody (240983C9)
{{$productOrderCtrl.translations['antibody.pdp.commerceCard.promotion.promotions']}}
{{$productOrderCtrl.translations['antibody.pdp.commerceCard.promotion.viewpromo']}}
{{$productOrderCtrl.translations['antibody.pdp.commerceCard.promotion.promocode']}}: {{promo.promoCode}} {{promo.promoTitle}} {{promo.promoDescription}}. {{$productOrderCtrl.translations['antibody.pdp.commerceCard.promotion.learnmore']}}
产品信息
83851-6-RR
种属反应
宿主/亚型
Expression System
分类
类型
克隆号
抗原
偶联物
形式
浓度
纯化类型
保存液
内含物
保存条件
运输条件
产品详细信息
Immunogen sequence: SDDSDSDER NSDGAVTQNK TNISTASATV SAATSTESIS TRKVLPMSIA RHNIAGTTHS GAEKDVDVSE DSPPPLPERT PESFVLASEH NTPVRSEWSE LQSQERSEQK KSEGLITSEN EKCDHPAGGI HYEMCIECPP TFSDKREQIS ENPTEATDIG FGNRCGKPKG PRDPPSEWT
靶标信息
PTP PEST is an 88 kDa cytosolic protein tyrosine phosphatase which is ubiquitiously expressed in mammalian tissues. PTP PEST exhibits a high specific activity when assayed in vitro with artificial tyrosine-phosphorylated substrates. PTP PEST is subject to regulation via phosphorylation of ser 39 and is catalyzed by both protein kinase C and protein kinase A.
仅用于科研。不用于诊断过程。未经明确授权不得转售。
篇参考文献 (0)
生物信息学
蛋白别名: pest; Protein-tyrosine phosphatase G1; PTP-PEST; PTPG1; tcag7.1075; Tyrosine-protein phosphatase non-receptor type 12
基因别名: PTP-PEST; PTPG1; PTPN12
UniProt ID: (Human) Q05209
Entrez Gene ID: (Human) 5782